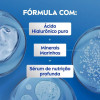
Loção Corporal Nivea Body Hidratante Pele Normal 200ml

Loção Corporal Nivea Body Hidratante Pele Normal 200ml é um produto do tipo loção hidratante corporal, com apresentação de 200ml. Foi desenvolvida para hidratar e ajudar no cuidado diário da pele. Sua textura favorece a aplicação prática e o uso contínuo na rotina de cuidados. Aplicar sobre a pele limpa e seca, massageando até completa absorção. Uso externo.
Loção Corporal Nivea Body Hidratante Pele Normal 200ml









-350x350.jpg)











-350x350.jpg)
-350x350.jpg)















-350x350.jpg)

















